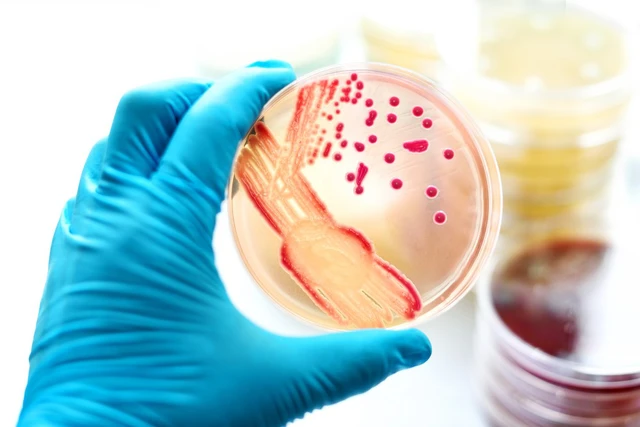
Nguyên nhân và biến chứng khi bị hội chứng nhiễm trùng

Nền tảng công nghệ, dịch vụ số và hệ sinh thái Trung Global
Theo dõi TVN trên
Lưu trữ
Chọn tháng Tháng 7 2025 (74)
Tháng 6 2025 (6)
Tháng 5 2025 (12)
Tháng 4 2025 (52)
Tháng 3 2025 (96)
Tháng 2 2025 (53)
Tháng 1 2025 (121)
Tháng 12 2024 (72)
Tháng mười một 2024 (210)
Tháng 10 2024 (139)
Thẻ
Chọn Thẻ
“anh em” của Bitcoin (1)
1 tỷ đô la (1)
1 vào 8 ra (1)
10 năm độc thân (1)
10.5 tỷ đô la (1)
100 năm (1)
100inch (1)
20 mẫu xe (1)
2024 (1)
2025 (7)
2025 đầu tư gì (1)
2025 nên đi đâu (1)
3 khái niệm (1)
5 Series (1)
50 vụ tấn công (1)
500+ câu hỏi (1)
5G (1)
6/3/2025 (1)
911 (1)
Á hậu Thụy Vân (1)
A Tổ (1)
Agribank (1)
AI (4)
AI 2025 năm sau (1)
AI giá rẻ (1)
Ai là triệu phú (1)
AI năm 4050 (1)
Ai thay Putin (1)
AI Trung Quốc (1)
AI và bộ não người (1)
AI và con người (2)
AI viết code (1)
Air Blade (1)
Air Blade 2025 (1)
Albert Einstein (1)
Album “Bướm Trắng” (1)
Alibaba (1)
Altcoin Season (2)
âm mưu (1)
âm thanh đỉnh cao (1)
Âm thanh số (1)
Ẩm thực Tây bắc (3)
Ẩm thực Việt (8)
Ẩm thực Việt Nam (1)
An Nguy (1)
Analog (1)
Angela Merkel (1)
Angela Phương Trinh (1)
Ảnh cưới (1)
ảnh cười (1)
Ảnh đẹp (1)
ảnh đẹp (1)
Ảnh đẹp du lịch (1)
Ảnh du lịch (1)
Ảnh hoạt động (2)
Ảnh hưởng (1)
Anh Thơ (1)
Anh trai say hi (1)
Anhxtanh (1)
Anna Linh (1)
Áo vải (1)
Áp dụng (1)
Apple (4)
Apple của Trung Quốc (1)
Apple lớn mạnh (1)
Area 51 (1)
ATH (1)
Athens (1)
AttaPoll (1)
Audi (1)
Audio (2)
Bà xã kín tiếng (1)
Baba Vanga (1)
Backup Dữ Liệu (1)
Bài hát (1)
Bài hát yêu thích (0)
Bài phát biểu Trump (1)
Ballad (5)
Ballad 2024 (1)
Bản chất (1)
Bản chất Shark (1)
Bán chạy nhất (1)
Ban Đối ngoại Trung ương (1)
Bán Khống Bitcoin (1)
Bản nhạc (1)
Ban nhạc Queen (1)
Bàn phím cơ (1)
Bàn phím Fuhlen (1)
Bàn phím máy tính (1)
bản tin đầu tiên (1)
Bang California (1)
Bằng Cường (1)
Bảng giá xe (1)
Bảng mã màu (1)
Bảng màu css (1)
Bánh mỳ ngon (1)
Bánh mỳ Patê (1)
Bánh mỳ trứng (1)
báo cáo kết quả kinh doanh (1)
Bảo hiểm PVI (1)
Báo Nga (1)
Bảo Thy (1)
Bảo Vân (2)
Bảo vật quốc gia (1)
Bảo vệ mắt (1)
Bắt con lấy vợ (1)
Bắt đỉnh – đáy (1)
bất động sản (2)
Bất động sản 2025 (1)
bắt sóng thị trường (1)
Bật tắt PC (1)
Bật tắt PC từ xa (1)
BĐS 2025 (1)
BĐS HN TP.HCM (1)
Bẻ cong (1)
Bẻ cong không gian (1)
bệnh đường tiết niệu (1)
Bệnh sởi (1)
Bennu (1)
Berkshire Hathaway (1)
Bernie Sanders (1)
Bí ẩn (2)
Bí ẩn khoa học (2)
Bí ẩn vũ trụ (1)
Bi kịch (1)
Bí mật (2)
Bí quyết đầu tư (1)
Bí Quyết Thành Công (1)
Bích Thuỷ (1)
Bích Tuyền (1)
Biden (1)
Biến động giá vàng (1)
Biến mất (1)
Biến mất khỏi công chúng (1)
Biển quảng cáo (0)
Biên tập viên (1)
biệt thự (1)
Biệt thự Bảo Thy (1)
Biểu đồ nến (2)
Biểu tượng công nghệ (1)
Biểu tượng điện tử (1)
BigBang (1)
BigBang có thật ko (1)
Bill Gates (1)
Bình Dương (1)
Bios (1)
Bios là gì (1)
Bios trong máy tính (1)
Bitcoin (2)
Björk (1)
BKAV (1)
Blake Shelton (1)
Blockchain (2)
Blockchain là gì (1)
BMW (1)
BMW 5 Series (1)
Bộ chuyển đổi (1)
Bộ não con người (1)
Bộ não máy tính (1)
Bộ não người (2)
Bộ não nhân tạo (1)
Bổ nhiệm (1)
Bộ nhớ 16GB (1)
Bộ óc vĩ đại (1)
bốc đầu xe (1)
Bolero (7)
Bollinger Bands (1)
Bóng đá Việt Nam (1)
Box phone (1)
BTC Dominance (1)
BTV gợi cảm (1)
BTV Hoài Anh (1)
BTV Hữu Bằng (1)
BTV Khánh Trang (1)
BTV Mai Ngọc (1)
Btv Mạnh Cường (1)
BTV Ngọc Trinh (1)
BTV Nguyễn Minh Hà (1)
BTV nổi tiếng (1)
BTV Phương Thảo (1)
BTV Quản Vân Anh (1)
BTV Quang Minh (1)
BTV Quốc Anh (1)
BTV thời sự (4)
BTV Thu Hà (1)
BTV VTV (1)
BTV xinh đẹp (1)
Bún bò Huế (1)
Bún cá (1)
Bún cá ngon (1)
Bún chả (1)
Bún chả Hà Nội (1)
Bún đậu mắm tôm (1)
Bún mắm (1)
Bún mọc (1)
Bún Ốc (1)
Bún riêu cua (1)
Bún thang (1)
Bước chuyển mình (1)
Buổi chia sẻ (1)
Busta Rhymes (1)
Bưu chính viễn thông (1)
BVP (1)
Cà phê sữa đá (1)
Ca sĩ (6)
Ca sĩ nhạc chế (1)
Ca sĩ Phương Linh (5)
Ca sĩ triệu view (1)
Các chuẩn kết nối (1)
Các dòng tivi (1)
Các đuôi file (1)
Các ic số (1)
các linh kiện (1)
Các loại hạt (1)
Các loại sóng (1)
Các mẹo hay (1)
Các mẹo máy tính (1)
Các nền tảng (1)
Các nghịch lý (1)
Các phím tắt (1)
Các tập lệnh (1)
Cách áp dụng (1)
cách bật FaceTime (1)
Cách chơi XM (0)
Cách chọn loa (1)
Cách kiếm tiền 2025 (1)
Cách kiếm tiền của nhà cái (1)
Cách làm (1)
Cách làm nhà cái (1)
Cách nấu (5)
cách nhận biết (2)
Cách phòng ngừa (1)
Cách sử dụng (5)
Cách tạo (1)
Cách truy cập (1)
Caffee nâu đá (1)
Cái chết (1)
Cải lương (1)
Cài và Cấu Hình (1)
California (1)
Cẩm Ly (1)
Cẩm nang du lịch (1)
Cẩm Tú Cầu (1)
Camera (1)
Camera an ninh (1)
Cân bằng lệnh (1)
Cần biết (1)
căn nhà rộng 40m2 (1)
căng thẳng (1)
Cánh cổng vũ trụ (1)
Cánh cửa khám phá (1)
Cao tốc TP.HCM (1)
Cấp độ 7 (1)
Cấp độ 9 (1)
Cấp độ II (1)
Cập Nhật 2025 (1)
Card đồ họa (1)
Cardano (ADA) (1)
Carlos Slim (1)
CASA (1)
Casper (1)
cậu bé nghèo (1)
Câu đố vui (1)
Câu hỏi (1)
Câu hỏi vui (1)
Câu lệnh lập trình (1)
Câu lệnh phổ biến (1)
Cấu Tạo (4)
CĐ Nghề Vĩnh Phúc (1)
CEO đồng nghiệp (1)
CEO Sundar Pichai (1)
Ceo Vinamilk (1)
Chẩm chéo (1)
chăm sóc sức khỏe (1)
Chân dung MC (2)
Chân dung nữ BTV (1)
Chặn xe vợ cũ (1)
Chào buổi sáng (1)
Cháo dinh dưỡng (1)
Chất liệu (1)
Chất liệu làm loa (1)
châu Âu (1)
Cháu gái Kim Tiểu Long (1)
Châu Khải Phong (1)
Chạy ngay đi (1)
Cháy xe (1)
Chế (1)
Chế độ (1)
Chỉ báo MACD (2)
chỉ báo RSI (1)
Chị Đẹp (1)
Chi Pu (1)
chi thưởng (1)
Chi Tiết 2025 (1)
Chi Xê (1)
Chia tay (1)
Chiến lược Binaryoption (1)
Chiến lược cao cấp (1)
chiến lược đầu tư (1)
Chiến tranh (2)
Chiêu trò nhà cái (1)
chiêu trò thao túng (1)
chính sách (1)
Chip bán dẫn (1)
Chip M4 (1)
Chợ chuyền thóing (0)
Chợ chuyền thống (1)
chợ hoa xuân (1)
Cho Người Không Chuyên (1)
Cho Người Mới (3)
Chợ quê (1)
Chợ Thạch Đà (1)
Chợ Việt Nam (1)
chồng bác sĩ (1)
Chồng Bảo Thy (1)
Chồng cũ (1)
Chồng đại gia (1)
chồng diễn viên (1)
Chống độc quyền (1)
chồng kém tuổi (1)
Chống tham nhũng (1)
Chống xuất tinh sớm (1)
Chu Bin (1)
Chu Du (1)
Chủ lực (1)
Chủ lực làm làm nhà cái (1)
Chu Thúy Quỳnh (7)
Chủ tịch (1)
Chủ tịch hòa phát (1)
Chủ tịch nước (4)
chưa ai vượt qua (1)
Chưa có lời giải (1)
Chưa giải mã (2)
Chưa lời kết (1)
Chưa thể giải thích (2)
Chuẩn kết nối (1)
Chức năng bios (1)
Chung Cư (1)
chung kết Asian Cup (1)
Chứng khoán (4)
Chung Tũn (9)
Chương trình chào buổi sáng (1)
Chương trình Tết (1)
Chút tình dạ cổ (1)
chuyển host WordPress (1)
Chuyện kết hôn (1)
Chuyện lạ có thật (1)
CLB Bình Dương (1)
CMC (1)
Cơ Bản (2)
Cơ Bản 2025 (1)
Cơ chế (1)
Cổ phiếu (1)
Cổ phiếu 2025 (1)
Cổ phiếu CII (0)
cổ tức (1)
Coffe Hà Nội (1)
Coffee (1)
Coffee đợi một người (1)
Coffee hút khách (1)
Coffee muối (1)
Coffee Trung Nguyên (1)
coin (1)
Con bài (1)
Con bài ông Trump (1)
Con gái 1 tuổi (1)
Con gái Kim Jong Un (1)
con gái xinh (1)
Con người bất tử (1)
Con tàu ánh sáng (1)
Công an Thành phố (1)
Cổng Audio (1)
Công cụ (1)
Công cụ AI (1)
Công cụ đầu tư (1)
Công cụ tổ chức (1)
Công cụ viết code (1)
Công Dương (1)
Cổng kết nối (1)
Công khai (1)
Công nghệ (3)
Công nghệ & giải trí (1)
Công nghệ 2025 (1)
Công nghệ AI (4)
công nghệ âm thanh (1)
công nghệ chuỗi khối (1)
công nghệ động cơ (1)
công nghệ Hàn Quốc (2)
công nghệ hình ảnh (1)
Công nghệ không gian (1)
Công nghệ nhân loại (1)
công nghệ Nhật Bản (2)
Công nghệ nổi bật (1)
Công nghệ sinh học (1)
Công Nghệ Tiên Tiến (1)
công nghệ toàn cầu (1)
công nghệ Trung Quốc (1)
công nghệ tương lai (6)
Công nghệ vi mạch (1)
Công nghiệp (0)
Công thức điện (1)
Công thức điện tử (1)
Công thức nấu (3)
Công ty cổ phần (1)
công ty du lịch (1)
Công ty Five A (1)
Công ty sữa (1)
Cong Ty Thành Công (1)
Công Ty TNHH (1)
Công ty Viettel (1)
Contact (0)
Cover (2)
COVID-19 (1)
Cryptocurrency (1)
Cú bắt tay 1.5 tỷ USD (1)
của Facebook (1)
Cục đẩy (1)
Cục đẩy liền vang (1)
cực dễ (1)
cúng Công ông Táo 2025 (1)
cúng đầu năm (1)
Cung đường phượt (2)
cúng ông Công ông Táo (3)
Cuộc chiến Nga – Ucraina (2)
Cuộc chiến pháp lý (1)
Cuộc chiến toàn diện (1)
Cuộc đời (1)
Cuộc đổi đời (1)
Cuộc sống AI và người (1)
Cuộc sống MC (1)
cuộc trò chuyện (1)
Custom Post Type (1)
Cừu Dolly (1)
đa chuỗi tiềm năng (1)
Đa quốc gia (6)
Đa vũ trụ (1)
đắc cử (1)
Đặc điểm sóng (1)
Đắc Nhân Tâm (1)
Đặc sản Hà Nội (1)
Đặc sản miền tây (1)
Đặc sản Việt Nam (1)
Đặc trưng Huế (1)
DAC và ADC (1)
Daewoo (1)
dải Bollinger (1)
Đài THVN (1)
Đài Truyền hình (1)
Đại tướng (1)
Đại tướng Phan Văn Giang (1)
Đàm Vĩnh Hưng (3)
Dân ca (1)
Dân ca xứ nghệ (1)
Đan Nguyên (1)
Đan Trường (2)
Đăng ký cử tri (1)
Đặng Lê Nguyên Vũ (1)
Đấng Nam Nhi (1)
Đặng Thành Tâm (1)
dành cho ngân hàng (1)
Danh mục (1)
Danh Tuấn Trung (1)
Đào Anh Thư (1)
Đào Hiền Thục Anh (1)
Đào Pi (1)
đào tạo giáo viên (1)
Darwin (1)
Đạt Ozy (1)
Đầu đủ nhất (1)
Dấu hiệu (1)
Đầu tư (2)
Đầu tư 2025 (1)
Đầu tư coin (1)
Đầu tư Đà tăng trưởng (1)
đầu tư hiệu quả (2)
đầu tư tài chính (2)
Đầu Tư Tài Chính (1)
David Geffen (1)
Đầy đủ (1)
Đầy đủ nhất (2)
dạy học ngoại ngữ (1)
Đẩy liền vang (1)
dạy thêm (1)
Dế Choắt (1)
Đèn led (1)
Đèn led hỏng (1)
Đèn led tự tắt (1)
đẹp ngỡ ngàng (1)
Đẹp nhất (1)
ĐH Sư phạm Hà Nội (1)
đi bộ (1)
Di động (1)
Đi theo xu hướng (1)
Địa chỉ bán (2)
Địa chỉ Hà Nội (1)
Địa chỉ thực (1)
Diana Ross (1)
Dịch vụ (2)
Dịch vụ tên miền phụ (1)
Điểm đến 2025 (2)
Điểm đến hấp dẫn (1)
Điểm đến Việt Nam 2025 (1)
Điểm mua sắm (1)
Điểm nóng chảy Kiev (1)
Điện (1)
Diện áo dài (1)
Điện dân dụng (0)
Điện thoại (3)
Điện thoại 2025 (1)
Điện thoại AI (2)
Điện thoại di động (1)
Điện thoại lượng tử (1)
Điện thoại Samsung (1)
Điện thoại sinh học (1)
Điện thoại tốt nhất 2025 (1)
Điện thoại vivo (1)
Điện tử (1)
Điện tử cơ bản (2)
điện tử Trung Quốc (1)
Diễn viên (1)
Diễn viên 2k2 (1)
Diễn viên giờ vàng (1)
Diễn viên hài (4)
Diễn viên hài Thái Sơn (1)
Diễn viên Kim Tuyến (1)
Diễn viên Lý Hùng (1)
Diễn viên Từ Hy Viên (1)
Diệp Lâm Anh (1)
Dierks Bentley (1)
Điều bất thường (1)
Điều cần biết (1)
Điều khiển PC (1)
Điều khiển tivi (1)
Điều khiển từ trái đất (1)
Điều teij (0)
Điều trị bệnh sởi (1)
Digital (2)
Digital Gold (1)
Định chế tài chính (0)
đính chính (1)
Đình dũng (1)
Định hình tương lai (1)
Đinh Tiến Dũng (1)
DIY (1)
Dj Nysaki (1)
Đỗ Duy Nam (4)
Đỗ Hoàng Minh Khôi (1)
Độ rộng vũ trụ (1)
Đố vui (1)
Đoàn Lâm (1)
Doanh nghiệp Việt (2)
Doanh thu (1)
doanh thu du lịch (1)
doanh thu du lịch nghìn tỷ (1)
Độc đáo (1)
Dogecoin (DOGE) (1)
đổi đời ngoạn (0)
Đợi một người thạch đà (1)
Đối thủ Mai Phương Thúy (1)
Đời thực (1)
Đời tư (1)
Đòn hủy diệt (1)
donal trump (1)
Donald Trump (5)
Dòng chảy lịch sử (1)
Động cơ (1)
Động Cơ Ion (1)
Động cơ phản vật chất (1)
Động cơ Plasma (1)
động cơ tương lai (1)
Dòng họ quyền lực (1)
Đồng hồ thông minh (1)
Đồng Libra (1)
Đông Nhi (1)
Dòng rò (1)
đồng Tether (1)
đồng tiền “meme” (1)
đồng tiền điện tử (2)
Đồng usd (1)
Đồng usd mất giá (1)
Đột phá (3)
Đột phá y học (1)
Dowload (1)
Downtrend (1)
Dư âm lịch sử (1)
Dự báo (2)
Dự báo giá vàng (1)
đu đỉnh (1)
Du hành thời gian (2)
du hành vũ trụ (1)
Du lịch (1)
Du lịch 2025 (2)
du lịch ẩm thực (1)
du lịch Tết Ất Tỵ (1)
du lịch theo dấu chân (1)
Du lịch Việt Nam 2025 (1)
Dữ liệu kinh tế (1)
Dữ liệu vĩ mô (1)
đưa tiếng Anh (1)
Đức Châu (1)
Dũng Hớn (6)
Đừng Nói Yêu Tôi (1)
được ưa chuộng (1)
Đuôi file (1)
Đuôi file phổ biến (1)
Dương Hồng Loan (1)
Dương Ngọc Thái (1)
Đường Trung Bình Động (1)
Đường xu hướng (3)
Duy AV (1)
Duy Khánh (1)
Duy Mạnh (1)
ĐVH (1)
E Class (1)
E-Coffee (1)
EDM (1)
Elliott Wave (1)
Elon Musk (2)
Elon Musk phát biểu (1)
Em gái Tôn Quyền (1)
EMA (1)
Emmanuel Macron (1)
EQ cao (1)
ETH là gì (1)
Ethereum (1)
EVN (1)
Exness (0)
FaceTime (1)
FaceTime là gì (1)
Fashion Week (1)
Fibonacci (1)
Five A Phú Quốc (1)
FOMO là gì FUD là gì (1)
Forex dễ hay khó (1)
FPT (2)
Fuhlen (1)
Futures Trading (1)
Gà (1)
Gà đen (1)
Gà đông tảo (1)
Gã khổng lồ (10)
Gái Tuyên Quang (1)
Gặp sự cố (1)
GDP của Mỹ (1)
gen Z (1)
Giá bất động sản (1)
Gia Cát Lượng (6)
Giá gà đông tảo (1)
Giả lập (1)
Giá sầu riêng (1)
Giả thuyết (1)
Gia tộc Rothschild (1)
Giá vàng (5)
Giá vàng 6/3/2025 (1)
Giá vàng nhẫn (1)
Gia vị (1)
Giá xăng (1)
Giá xăng tăng (1)
giá xe Mini (1)
giá xe Peugeot (1)
Giải mai vàng (1)
Giải thích (1)
giảm cân (1)
giảm phát thải (1)
Giảm show một nửa (1)
Giảng dạy (1)
Giáng Tiên (1)
Giao dịch (1)
giao dịch hiệu quả (1)
Giao Dịch Tài Chính (1)
Giao dịch vàng (0)
Giáo trình (1)
Giới khoa học (1)
Giới thiệu (1)
Giới thiệu SSI (1)
Giới thiệu Viettel (1)
Giọng ca để đời (1)
giọng hát đặc biệt (1)
Giọng hát triệu view (1)
Giống nhau (1)
giữ kỷ lục (1)
Gmobile (1)
Góc ít biết (1)
Gói cước 5G (1)
Google (2)
Google docs (1)
Google Sheet (1)
Google tài liệu (1)
Google Tivi (1)
GS Cù Trọng Xoay (1)
GS. Richard Henry (1)
GTEL (1)
gương mặt yêu thích (1)
Hà Myo (1)
Hà Nội (2)
Hà Nội trong vũ trụ (1)
Hà Việt Dũng (1)
Hài (3)
Hài 2024 (10)
hài hước (1)
Hải Phòng (1)
hải quân Việt Nam (1)
Hài triệt view (1)
Hai trong một (1)
Hàn Hằng (1)
Hàn Quốc (2)
Hàn Trang (2)
Hana Cẩm Tiên (1)
hàng đầu thế giới (1)
Hành động chặn xe (1)
Hành trình (2)
Hạt cơ bản (1)
hát cùng Ngô Kiến Huy (1)
Hạt electron (1)
Hạt nhân (1)
hạt nhân lan tỏa (1)
Hạt thần kỳ (1)
Hát về bác (1)
Hậu Putin (1)
Hay dùng (1)
Hè 2025 (1)
He Always Smiles (1)
Hệ điều hành (1)
Hé lộ bí ẩn (1)
Hệ mặt trời (1)
hệ sinh thái (1)
Hệ thống âm thanh (1)
hẹn hò (1)
Hi End (1)
Hi Fi (1)
Hiện nay (2)
Hiện thân (1)
Hiện thực (1)
Hiền Thục (1)
Hiện tượng khoa học (1)
Hiện tượng mạng (1)
Hiện tượng mạng Lệ rơi (1)
Hiểu Và Sử Dụng (1)
Hình nền (1)
hình nền đẹp (2)
Hình nền desktop (1)
hình nền miễn phí (1)
Hit (1)
Hitachi (1)
Hố đen (2)
Hồ Ngọc Hà (1)
Hồ Phương Trang (7)
Hồ Quang Hiếu (1)
Hồ Quỳnh Hương (1)
hồ sơ phá án (1)
Hố trắng (1)
Hỗ Trợ (1)
Hỗ trợ và Kháng cự (2)
Hồ Việt Trung (1)
Hoa hậu Ngọc Hân (1)
Hoa hậu Việt Nam (1)
Hòa Minzy (2)
hoa Tết (1)
hoa Tết 2025 (1)
Hóa thân (1)
Hoài Lâm (1)
Hoàng Anh Tuấn (1)
Hoàng Lan (1)
Hoàng Minh (1)
Hoàng Trung (1)
Hoạt động (2)
Hoạt động nghệ thuật (1)
Hoạt động ngoại khóa (1)
học thêm (1)
Học thuyết hạt nhân (1)
hội chứng nhiễm trùng (1)
Hội đàm (3)
hỏi đáp (1)
Hon đa SH 2025 (1)
Hôn nhân (1)
Hôn nhân đời thực (1)
Honda (2)
Honda 2025 (1)
Honda biz (1)
Honda biz 2025 (1)
Honda Vario (1)
Hồng Năm (1)
Hồng Vinh (1)
hợp đồng tương lai (1)
Hot girl (2)
Hot girl Trần Linh Hương (1)
Hot Tiktok (0)
Huawei (1)
Huawei Watch GT 5 Pro (1)
Huế (1)
Hướng của giá (1)
Hướng Dẫn Cách Vẽ (1)
Hướng Dẫn Chi Tiết (5)
Hướng Dẫn Cơ Bản (1)
Hướng Dẫn Sử Dụng (1)
Hướng dẫn Tạo (1)
Hương Tràm (1)
Huy Cuội (2)
Huy Cường (1)
Huyền Baby (1)
Huyền bí (1)
Huyền My (1)
Huyền thoại (1)
Huyền thoại công nghệ (1)
Huyền thoại kinh tế (1)
Huyền Trang (1)
Huyme (1)
Ic số (1)
ICO là gì (1)
infographic (1)
infographic là gì (1)
Initial Coin Offering (1)
Integrated Circuit Digital (1)
iPhone (1)
iPhone 16 pro (1)
Israel (1)
Isuzu (1)
Isuzu mu X Premium (1)
Ít Nhưng Dài Lâu (1)
Jack Ma (1)
James Web (1)
James Web mới nhất (1)
James Web phát hiện (1)
Jee Trần (2)
John Paulson (1)
JVC (1)
JVevermind (1)
Kardashev là gì (1)
Katy Perry (1)
Kế hoạch chi tiết (0)
Kế hoạch liên hợp (1)
Ken Griffin (1)
Kết nối (1)
Kết nối thiết bị (1)
kết quả tennis (1)
Khắc Việt (1)
khai hội chùa hương (1)
Khái niệm âm thanh (1)
Khái niệm phổ biến (1)
Khám phá (2)
Khám phá vũ trụ (1)
Kháng Cự (1)
Khánh Ly (19)
Khánh Phương (2)
Khảo sát kiếm tiền (4)
khen thưởng (1)
Khi nào có (1)
Khí nhà kính (1)
Khó tưởng tượng (1)
Khoa học (2)
Khoa học hiện đại (1)
Khoa học vũ trụ (1)
khoản nắm giữ (1)
Khoe con gái (1)
Khối lượng và giá (1)
Không gian (1)
không lên sóng (1)
không thể thiếu (1)
Không thời gian (1)
Khổng Tú Quỳnh (1)
Không tưởng (1)
Khu mua sắm (1)
Khu vực 51 (1)
Khu vực cấm (1)
khương dừa (1)
Khuyến cáo (1)
Kịch bản (1)
Kích hoạt OPcache (1)
Kiếm thẻ cào (1)
Kiếm tiền (1)
Kiếm tiền 2025 (1)
Kiếm tiền Forex (1)
Kiếm tiền Paypal (2)
Kiến thức (2)
kiến thức cần biết (1)
Kiến Thức Cơ Bản (1)
Kiến thức nền tảng (1)
kiêng gì ngày tết (1)
kiêng kị ngày tết (1)
Kiếp đỏ đen (1)
Kiev (1)
Kim Chi (1)
Kim Jong Un (1)
Kim Jong un và con gái (1)
Kim Tử Long (1)
Kinh nghiệm xương máu (1)
Kinh tế (1)
Kinh tế suy thoái (1)
Kính thông minh (1)
Kính viễn vọng (1)
Kobe (1)
Kursk (2)
Kỷ nguyên 4.0 (1)
ký quỹ (1)
Kỹ thuật cân bằng lệnh (1)
Kỹ thuật trade (2)
Lã Mông (1)
Lala Trần (1)
Làm ca sĩ (1)
Lâm Chấn Huy (1)
Làm cô dâu (1)
Lâm Đức Anh (10)
Lâm Hùng (1)
Lâm nguyệt Ánh (1)
Lâm Nhật Tiến (1)
Lâm Triệu Minh (1)
Làm việc với máy tính (1)
Làm website (0)
làng Nủ (1)
Lập trình AI (2)
Lập trình theme (1)
Lập trình web (1)
Laptop (2)
Laptop 2025 (1)
Laptop tốt nhất 2025 (1)
Lật tẩy (1)
Lê Bảo Bình (1)
Lệ Quyên (1)
Lệ rơi (1)
Lê Sang (1)
Lê Thơm (5)
LEMP cho VPS (1)
Lên xe hoa (1)
Lệnh trong vi điều khiển (1)
Lenovo 2024 (1)
Lenovo tốt nhất (1)
LG (1)
Lịch kinh tế (1)
Lịch sử (1)
Lịch sử loài người (1)
Lịch sử nhân loại (1)
Lịch thi đấu (2)
Liên hệ (0)
Liên khúc (10)
Linh Chi (1)
Linh Hương Luz (2)
Linh Hương Trần (3)
Linh kiện cơ bản (1)
Linh kiện điện tử (1)
linh kiện trên mạch (1)
Litecoin (LTC) (1)
Live Show Mới Nhất (1)
Lo Fi (1)
Lỗ giun (1)
Lỗ sâu (1)
Lỗ Túc (1)
Loa (1)
Loa âm trầm (1)
Loa Bass (1)
Loa Bass là gì (1)
Loa Bluetooth (1)
Loa Bluetooth là gì (1)
Loa Bookshelf (1)
Loa Coaxial (1)
Loa điện động (1)
Loa đồng trục (1)
Loa hiện đại (1)
Loa kèn là gì (1)
Loa mành tĩnh điện (1)
Loa Mid (1)
Loa Nén Là Gì (1)
Loa Plasma (1)
Loa Plasma là gì (1)
Loa siêu trầm (1)
Loa Soundbar (1)
Loa Soundbar là gì (1)
Loa Sub (1)
Loa Sub là gì (1)
Loa Thanh (1)
Loa TOA (1)
Loa TOA là gì (1)
Loa toàn dải (2)
Loa toàn dải là gì (1)
Loa Treble (1)
Loa Treble là gì (1)
Loa Trung (1)
Loại bỏ 99% (1)
Lỗi đèn led (1)
Lối đi (1)
Lời tiên tri (1)
Lợn mán (1)
Long Hách (7)
Loramen (1)
Lục Tốn (1)
Luhansk (1)
Luôn gọi điện (1)
Lương Bằng Quang (1)
Lương Cường (1)
Lương Gia Huy (1)
Lướt Sóng Đạp Mây (1)
Lưu Ánh Loan (1)
Lưu Bị (8)
Lưu trữ web (1)
Lý Cường (1)
Lý do thanh trừng (1)
lý do ưa chuộng (1)
Lý Hùng (1)
Lý Khắc Cường (1)
Lý Khắc Cường chết (1)
Lý thuyết (3)
Lý thuyết Dow (2)
Lý thuyết mới (1)
lý thuyết sóng (1)
MA (1)
Ma lực đồng tiền (1)
Mã màu chuẩn (1)
Mã màu css (2)
Mã Siêu (1)
Mã tháng 6 (1)
Mặc áo dài (1)
mặc gì ngày tết (1)
Mac Mini (1)
MACD Là Gì (1)
Mạch bảo vệ (1)
Mạch chia RCA (1)
Mạch chống dòng rò (1)
Mạch cơ bản (1)
Mạch điện tử (1)
Mai Kiều Liên (1)
Mai Ngọc và chồng (1)
Mai Thiên Vân (1)
mâm Porsche 911 (1)
mâm xe Porsche 911 (1)
Màn hình IPhone (1)
Màn hình LG (1)
màn hình máy tính (1)
Mạnh Quân (1)
Marathon (1)
Margin (1)
Mark Zuckerberg (2)
Martina McBride (1)
mát tay (1)
Mẫu nhí (1)
mâu thuẫn kinh tế (1)
Máy đào ATH (1)
Máy đào bitcoin (2)
Máy đào tiền ảo (1)
Máy quang khắc (1)
Máy tính (2)
Máy tính 2024 (1)
Máy tính bàn (1)
Máy tính bảng (1)
Máy tính để bàn (1)
máy tính Lenovo (1)
Máy tính lượng tử (1)
máy tính xách tay (2)
MBB (1)
MC (1)
MC Anh Tuấn (1)
MC Diễm Quỳnh (1)
Mc Đinh Tiến Dũng (1)
MC duyên dáng (1)
MC Hoàng Dương (1)
MC Hồng Nhung (1)
MC Hồng Phúc (1)
MC Khánh Trang (1)
MC Lại Văn Sâm (1)
MC Lan Chi (1)
Mc Mù tạt (1)
MC Mỹ Vân (1)
Mc Ngọc Bích (1)
MC Ngọc Vân (1)
MC Nguyên Khang (1)
MC nổi tiếng (1)
MC Phí Linh (1)
MC Tạ Bích Loan (1)
MC Thành Trung (1)
MC thời tiết (2)
Mc Thời tiết Ngọc Vân (0)
MC Thùy Linh (1)
Mc Thụy Vân (1)
MC Trần Hạnh Phúc (1)
MC Trần Hồng Ngọc (1)
Mc Việt Hà (1)
MC VTV (7)
MC xinh đẹp (1)
mẹ chồng nàng dâu (1)
Mê linh (1)
mẹ và bà ngoại (1)
Medvedev (1)
Mẹo hay (1)
Mẹo máy tính (1)
Mercedes Benz (1)
Mercedes Benz E Class (1)
MetaQuotes (1)
Michael Bloomberg (1)
Microcom (1)
Microcontroller (1)
Microprocessor (1)
Microsoft (2)
Minh Tít (2)
Minh Tuyết (1)
MINI Countryman (1)
Miss Intercontinental (1)
MMO (1)
Mô hình cốc tay cầm (1)
Mõ làng (37)
Mô phỏng (1)
Mở Rộng (1)
Mở rộng âm thanh (1)
Moaz BéBé (1)
MobiFone (1)
Mộc Châu (1)
Mộc san (1)
Mochii (1)
Mọi chất liệu (0)
Mọi hiện tượng (1)
Mọi lứa tuổi (1)
Mói nhất (1)
Mối quan hệ (2)
Món ăn bổ dưỡng (1)
Món ăn ngon (13)
Món ăn phổ biến (1)
Món mì nhật (1)
Món ngon dễ làm (1)
Món ngon Hà Nội (1)
Món ngon từ thịt mèo (1)
Mộng Hoa Sim (1)
Moscow (1)
Mp3 (1)
MT4 và MT5 (1)
mu X Premium (1)
Mua bán điện (0)
mưa lũ (1)
Mua sắm 2025 (1)
Mỹ (1)
Mỹ Tâm (1)
Mỹ Vân (1)
Nadella (1)
Nam MC (2)
Năng lượng sao (1)
Não người (1)
Nasa (1)
Nên đầu tư (1)
Nên học (1)
Nén không gian (1)
Nền tảng (3)
Nền tảng tương lai (1)
Nền tảng vượt trội (1)
Nền văn minh (4)
Nền văn minh cấp 10 (1)
Nền văn minh tiên tiến (1)
Nga (2)
Nga thần tốc (1)
ngân hàng (1)
Ngân Ngân (1)
Ngành điện (1)
ngành ô tô (1)
ngày càng sexy (1)
ngày tết kiêng gì (1)
Nghành y tế (1)
Nghệ sĩ hài (1)
Nghệ sĩ nhạc chế (1)
Nghệ Sỹ (1)
nghỉ việc VTV (1)
Nghịch lý khoa học (1)
Nghiên cứu dữ liệu (1)
Ngô Kiến Huy (2)
Ngô Quốc Linh (1)
Ngõ ra RCA (1)
Ngoại hạng Anh (1)
Ngọc Hân (1)
Ngọc Huyền (1)
Ngọc Thủy (2)
Ngọc Trinh (2)
Ngọc Vân VTV (1)
Ngon khó cưỡng (1)
Ngôn ngữ lập trình (2)
ngôn ngữ thứ 2 (1)
Ngừng phát sóng (1)
Người anh hùng (1)
Người cao tuổi (1)
Người đàn ông hát (1)
Người dùng VinFast (1)
Người không chết (1)
Người mẫu (1)
Người mẫu Ngọc Trinh (1)
Người máy hình người (1)
Người mới (1)
Người ngoài hành tinh (1)
Người nhân tạo (1)
người nhập cư Mỹ (1)
Người thứ 3 (1)
Người trên 60 tuổi (1)
Nguồn Cung Bất Động Sản (1)
Nguyên lý (3)
nguyên lý hoạt động (2)
Nguyễn Minh Tuấn (1)
Nguyên nhân (1)
Nguyên tắc cơ bản (1)
Nguyên tắc quan trọng (1)
Nguyên tắc trade (1)
Nguyên tắc vàng (1)
Nguyễn Thái Học (1)
Nguyễn Thị Phương Thảo (1)
Nguyễn Tú (2)
Nhà báo (1)
nhà báo VTV (1)
Nhà cái (1)
Nhà Đầu Tư (1)
nhà đầu tư (2)
Nhà hát Truyền hình (1)
Nhà mạng (1)
Nhà máy Z157 (1)
nhà sang (1)
Nhà thiết kế (1)
Nhà văn Nguyễn Ánh (1)
Nhạc (1)
Nhạc 7x 8x 9x (1)
Nhạc 8x 9x (5)
Nhạc AI (1)
Nhạc bất hủ (1)
Nhạc buồn (4)
Nhạc Cách Mạng (3)
Nhạc Chế (5)
Nhạc chế triệu view (1)
Nhạc đám cưới (1)
Nhạc đời (4)
Nhạc hải ngoại (4)
Nhạc Hoa Lời Việt (3)
Nhạc Hot (1)
Nhạc Lính (1)
Nhạc Quê Hương (1)
Nhạc sĩ (1)
Nhạc test loa (1)
Nhạc tiền chiến (1)
Nhạc Trẻ (14)
Nhạc trẻ xưa (2)
Nhạc trữ tình (5)
Nhạc Vàng (3)
Nhạc xưa (2)
Nhân giống vô tính (1)
Nhân loại (1)
Nhân loại và electron (1)
nhận nhiều chú ý (1)
Nhận ra (1)
nhan sắc hiện tại (1)
Nhan sắc tiểu thư (1)
Nhận show đi hát (1)
Nhân vật lịch sử (1)
nhanh chóng an toàn (1)
Nhanh Như Chớp (1)
Nhật Bản (6)
Nhật Kim Anh (1)
Nhật ký (1)
nhiễm trùng (1)
nhiễm trùng tiết niệu (1)
Nhiễm trùng tiểu (1)
Nhiệt độ mặt trời (1)
nhiều người mơ (1)
Những bí ẩn (2)
Những câu nói bất hủ (1)
những điều cần biết (1)
Những hiện tượng (1)
Những nguyên tắc (1)
Nicki Minaj (1)
Ninh Dương Lan Ngọc (1)
Nổi bật 2025 (1)
Nội dung (1)
Nội dung file index (1)
Nơi giấc mơ tìm về (1)
Nơi lưu giữ (1)
nổi tiếng nhất (1)
Nóng (1)
Noo Phước Thịnh (1)
Nơron (1)
Nơron não người (1)
Nơron thần kinh (1)
NSND Hồng Vân (1)
NSND Quốc Anh (1)
NSND Tự Long (1)
NSƯT Thái Sơn (1)
Nữ hoàng ballad (1)
Nữ MC (3)
nữ nhà báo (1)
Nữ thủ tướng (1)
Nửa năm trước (1)
Nước hoa khử mùi (1)
Nước hoa tốt nhất (1)
Nước Mỹ (1)
Nước Nga (1)
Nước ngọt (1)
Nước ngọt và cơ thể (1)
nước súc miệng (1)
nuôi bé mồ côi (1)
ở Hàn Quốc (1)
Ô tô (2)
ô tô (1)
Ô tô điện (2)
Oanh Tạ (5)
Olaf Scholz (1)
Ông hoàng nhạc việt (1)
Ông hoàng thời sự (1)
ông Lê Hoài Trung (1)
OPPO mới nhất 2024 (1)
Ôtô điện (1)
Paid Viewpoint (1)
Panama (1)
Panasonic (1)
PC (1)
PC 2024 (1)
PC 2025 (1)
PC tốt nhất (1)
PC tốt nhất 2025 (1)
Pennsylvania (1)
Peugeot (1)
Phạm Kim Long (1)
Phạm Minh Chính (1)
Phạm Quỳnh Anh (2)
Phạm Trưởng (1)
Phạm Vinh (1)
Phạm Xuân Quỳnh (1)
Phân biệt giao dịch (1)
Phân Loại (3)
Phân loại sóng (1)
Phan Mạnh Quỳnh (1)
Phần mềm (1)
Phân tích (1)
Phân tích chi tiết (1)
Phân tích kỹ thuật (11)
Phân tích nến nhật (1)
Phân tích và dự báo (1)
Phản ứng (1)
Phan Văn Giang (1)
Phản vật chất (1)
Phan Vũ Nhật Linh (1)
pháo điện Tết 2025 (1)
Phát hiện mới nhất (1)
Phát nhạc trực tuyến (2)
Phim ca nhạc (6)
phim giả tình thật (1)
Phim Hài (4)
Phim mới (1)
Phim ngắn (1)
Phím tắt (1)
Phím tắt máy tính (1)
Phim việt (1)
Phở (1)
Phổ biến (1)
Phó Thủ tướng (1)
Phỏng đoán (1)
Phong thủy (1)
Phóng viên Phương Huyền (1)
Phù điêu thời Minh Mạng (1)
Phú Lê (1)
Phụ nữ quyền lực (2)
Phương Lâm (1)
Phương Linh (5)
Phương Linh 2025 (1)
Phương Linh nói (1)
Phương Linh ở ẩn (1)
Phương pháp giao dịch (1)
phương tiện công cộng (1)
phương tiện giao thông (1)
Phương Trang (4)
Phượt (2)
Phượt 2025 (1)
Phượt là gì (1)
Pi Network (2)
PiaLinh (1)
Pin hạt nhân (1)
Pin không cần xạc (1)
Pin Trung Quốc (1)
Playlist (2)
PLP (1)
Polkadot (DOT) (1)
Porsche (1)
Porsche 911 (1)
Prama (1)
Price Action (1)
Pump & Dump (1)
Putin (2)
Putin bị tấn công (1)
Quả cầu Dyson (1)
Quà tết (1)
Quán caffe (1)
Quân đội (1)
Quan Vũ (2)
Quang Hà (1)
Quang Lê (1)
Quốc Anh (1)
Quốc Khoát (23)
Quốc Thiên (1)
quỹ cấp vốn (1)
Quyền Linh (1)
Quyền lực (1)
Quỳnh Nga (1)
Răn đe (1)
Randy (1)
Raper Nas (1)
RCA (1)
RCA stereo (1)
REE (1)
Remix (2)
remix 2025 (1)
Restore Dữ Liệu (1)
Ripple (XRP) (1)
Robert Durst (1)
Robot (1)
Robot AI (1)
Robot sống chung người (1)
Rock (1)
RSI là gì (1)
S.T Sơn Thạch (1)
Sạc dự phòng (1)
Sắc vóc đời thực (1)
Sắc vóc xinh đẹp (1)
Safari (1)
Saka Trương Tuyền (5)
Sầm uất (1)
Samdech Techo Hun Sen (1)
Samsung (2)
Samsung Galaxy A06 (1)
sàn DEX (1)
Sàn Exness (0)
Sàn forex (0)
Sàn Forex uy tín (0)
Sản phẩm 2025 (2)
Sản phẩm hot (1)
Sản phẩm hot 2025 (1)
Sản phẩm mới (1)
Sản phẩm vũ trụ (1)
Sàn uy tín (0)
Sàn vàng (1)
Sàn XM (0)
Sáng rồi tắt (1)
Sao hoả (1)
Sao việt (15)
Sáp nhập (1)
Sarmat (1)
Sát cánh cùng nhau (1)
Sầu riêng (1)
Sau Tết 2025 (1)
Scam (1)
SCB (1)
Seenderella (1)
Sergey Efremov (1)
SH 2025 (1)
SH 350i (1)
Shark (1)
Sharp (1)
Short Bitcoin (1)
Showbiz 9/8 (1)
Siêu cổ phiếu (1)
siêu to khổng lồ (1)
Siêu vượt âm (1)
sinh năm 2000 (1)
Siri (1)
Smartphone (3)
Smartphone điều khiển PC (1)
Smartphone điều khiển tivi (1)
Smartphone thay điều khiển (1)
Smartphone ứng dụng (1)
Snoop Dogg (1)
sơ đồ mạch (1)
So sánh (1)
Sởi (1)
Sơn Đần (9)
Sơn Tùng M-TP (1)
Sống bình yên (1)
Sóng Elliott (1)
Sóng hấp dẫn (1)
Sống mãi (1)
Sống mãi không chết (1)
Sóng trong vật lý (1)
Soobin Hoàng Sơn (1)
Spot (1)
SSI (1)
Steve Jobs (1)
Stress (1)
Sự bất tử (1)
Sự biến động (1)
Sự cố đèn led (1)
Sự đột phá (1)
Sử dụng Duplicator (1)
Sử Dụng Hiệu Quả (2)
Sử Dụng MACD (1)
Sự kết hợp (2)
Sự khác biệt (1)
Sự nghiệp (3)
Sự sống (1)
Sự sống ngoài hành tinh (1)
Sự thật (4)
Sự xuất hiện (1)
Sửa chữa (0)
subwoofer (1)
Surveyon (1)
Tác hại của nước ngọt (1)
Tài chính (1)
Tai nghe Bluetooth (1)
Tài sản (1)
Tái sinh (1)
Tam quốc (25)
tâm sự (1)
Tâm trạng (2)
Tấn công Israel (1)
Tân Thủ tướng (1)
Tần Thuỷ Hoàng (1)
Tăng Thanh Hà (1)
tăng tốc WordPress (1)
tăng trưởng (2)
Tào Phi (1)
Táo quân 2025 (1)
Tào Tháo (8)
Tập Cận Bình (2)
Tập đoàn (3)
Tập đoàn Apple (1)
Tập đoàn công nghệ (3)
Tập đoàn Daewoo (1)
Tập đoàn HITACHI (1)
Tập đoàn hòa phát (1)
Tập đoàn Honda (1)
Tập đoàn Huawei (1)
Tập đoàn JVC (1)
Tập đoàn LG (1)
Tập đoàn Panasonic (1)
Tập đoàn Samsung (1)
Tập đoàn Sharp (1)
Tập đoàn Sony (1)
Tập đoàn TCL (1)
Tập đoàn TOSHIBA (1)
Tập đoàn Toyota (1)
Tập đoàn viễn thông (4)
Tập đoàn Xiaomi (1)
Tập tin cần thiết (1)
Tất Tần Tật (4)
Tàu ánh sáng (1)
Tàu vũ trụ (1)
Tàu Vũ Trụ Voyager (1)
Taxi (1)
taxi VinFast (1)
Taxi Xanh SM (1)
TCL (1)
Teader (0)
Teamplate (1)
Tên lửa hạt nhân (1)
Tên lửa Nga (2)
Tên lửa Sarmat (1)
Tên miền phụ (1)
Tesla (1)
tết âm lịch (3)
Tết Âm Lịch 2025 (1)
Tết Ất Tỵ (1)
Tết di sản (1)
Tết đoàn viên (1)
Tết Hà Nội 2025 (1)
Tết nguyên đán (2)
Tết vươn mình (1)
TH Tiến Thịnh (1)
thả cá chép (1)
THAAD (1)
Thạch đà (1)
Thái Dương (40)
Thái Học (1)
Thái Sơn (4)
Thang đo Kardashev (2)
Thang Kardashev (2)
Thang tiến hóa (1)
Thành công (1)
Thanh Duy (1)
Thành phố Hải Phòng (1)
Thanh Quý (1)
Thành tiêu y học (0)
thanh trừng (1)
Thành tựu 2025 (2)
Thành tựu khoa học (1)
Thành tựu y học (2)
Thao túng (1)
Thầy Khải (1)
Thay thế (1)
Thay thế s (0)
Thay thế smartphone (1)
Thế giới (2)
thế giới crypto (1)
Thế giới thực (1)
thế hệ thứ ba (1)
Thế Sơn (1)
Thêm website (1)
Theme Wordpress (3)
Theo Xu Hướng (1)
Theo yêu cầu (0)
Thi công quảng cáo (0)
Thi quốc tế (1)
thị trường (1)
Thị trường chứng khoán (1)
Thị Trường Crypto (3)
thị trường hoa Tết (1)
thị trường tài chính (1)
Thiên Nhân Đức (1)
Thiên tài (1)
Thiên Tú (3)
Thiết bị (1)
Thiết bị âm thanh (1)
Thiết bị điện tử (1)
Thiết bị tương lai (1)
Thiết kế web (0)
thiếu ngủ (1)
Thịt bò Kobe (1)
Thịt lợn (1)
Thịt mèo (1)
Thoái Lui (1)
Thời Đại Số (1)
Thời gian (1)
Thời gian ra mắt (1)
Thời gian xuất hiện (1)
Thời sự (2)
Thông dụng (1)
thông tin (1)
Thư chúc mừng (1)
thứ hai thế giới (1)
Thu Hiền (1)
Thủ khoa diễn viên (1)
Thử nghiệm (1)
Thu Thảo (1)
thủ thuật hay (6)
thủ tục hành chính xanh (1)
thủ tướng (1)
Thủ tướng Đức (2)
Thủ tướng Phạm Minh Chính (2)
Thủ tướng Trung Quốc (2)
Thừa Thiên – Huế (1)
Thục Anh (30)
Thực chiến (3)
Thực tế (1)
Thực tế hay viển vông (1)
Thức uống đậm đà (1)
Thức uống Huế (1)
Thùng loa đẹp (1)
Thùng loa toàn dải (1)
Thuốc sinh lý (1)
thuộc tính sản phẩm (1)
Thường áp dụng (1)
Thương Cin (1)
thương hiệu loa TOA (1)
Thương hiệu ô tô (1)
Thương Ly Biệt (1)
Thùy Dung (1)
Thùy Dương (2)
Thủy Kính (1)
Thùy Linh VTV (1)
Thúy Nga (1)
Thúy Quỳnh (1)
Thụy Vân (1)
Thuỵ Vân (1)
Thuyết âm mưu (1)
Thuyết tiến hóa (1)
Thuyết trái đất phẳng (1)
Thuyết tương đối (2)
Tiền ảo (5)
Tiền điện tử (6)
Tiên tri (2)
Tiểu hành tinh (1)
Tiểu sử (4)
TikToker (7)
TikToker Bảo Vân (1)
Tiktoker Chu Thúy Quỳnh (1)
TikToker Jee Trần (1)
TikToker Linh Chi (1)
TikToker Mochii (1)
Tiktoker Ngân Ngân (1)
TikToker Oanh Tạ (1)
TikToker Yến Thanh (1)
Tim Cook (1)
Tìm hiểu (7)
Tìm Hiểu Chi Tiết (14)
Tìm hiểu công nghệ (1)
Tìm hiểu tham vọng (1)
Tìm hiểu từ A-Z (1)
Tìm hiểu vũ trụ (1)
Tín chỉ carbon (1)
Tin vắn (1)
TIN VPOP (1)
Tình báo Ukraine (1)
tình đơn phương (1)
Tinh hoa ẩm thực (1)
Tinh hoa vũ trụ (1)
Tình trạng việc làm (1)
Tivi (4)
Tivi 100inch (1)
Tivi 2025 (2)
Tivi đáng mua nhất (1)
Tivi tốt nhất (1)
Tivi tốt nhất 2025 (1)
Tivi Xiaomi (2)
Tô Lâm (2)
Toàn bộ kiến thức (1)
Toàn cầu (3)
Toàn tập (2)
Tốc độ ánh sáng (1)
Tóm BigBang (1)
Tôn Quyền (5)
Tổng bí thư (2)
Tổng hợp (3)
Tổng quan (3)
Tổng thống (1)
Tổng thống Biden (1)
Tổng thống Mỹ (1)
Tổng thống Pháp (1)
Tổng thống Trump (2)
TOP 10 (1)
Top hit (2)
Tốp Laptop (1)
Top nghịch lý (1)
Toshiba (1)
Tốt cho mắt (1)
Tốt nhất 2025 (1)
Toyota (1)
TP HCM (1)
TP.HCM (1)
trả thù (1)
Trade (2)
Trade Coin (1)
Trader (4)
Trader thành công (1)
Trading (1)
TradingView là gì (1)
Trái đất (1)
Trái đất phẳng (1)
Trải nghiệm (2)
trải nghiệm sản phẩm (1)
Trải qua (1)
Trầm cảm (1)
trạm sạc VinFast (1)
Trần Cung (1)
Trần Đình Long (1)
Trần Hồng Hà (1)
Trần Linh Hương (1)
Trần Phương Hoa (1)
Trấn Thành (1)
Trang Abby (12)
Trang Emma (1)
Trang Pháp (1)
Trang phục Kim Jong Un (1)
Tranh cãi đạo đức (1)
tránh sai lầm (1)
Trao đổi (0)
trên iPhone (1)
Trên thị trường (1)
Trendline (1)
Trí tuệ AI (3)
Trí tuệ nhân tạo (1)
Trí tuệ nhân tạo – AI (1)
Triệu chứng (1)
Triệu Lệ Dĩnh (1)
Triều Tiên (2)
Triệu Tử Long (2)
Triệu Vân (1)
Triệu view (2)
trình diễn áo dài (1)
Trịnh Đình Quang (1)
Trình độ chuẩn được đào tạo (1)
Trợ cấp (1)
Trợ cấp 2025 (1)
trở lại màn ảnh (1)
Trong âm thanh (3)
Trọng Tấn (1)
trong WooCommerce (1)
Trump (6)
Trump khen Tim Cook (1)
Trump phát biểu (1)
Trung Đông (1)
Trung Ếch (2)
Trung Hoàng (1)
Trung nguyên (0)
Trung Quốc (1)
Trung Ruồi (51)
TrungvuNet (1)
Trương Hựu Hiệp (1)
Trương Phi (2)
Trương Phương (1)
Trường Sơn (6)
truyền hình (1)
truyền hình Tết (1)
truyền hình VTC (1)
truyền tải điện (1)
Truyền thông (1)
TT Putin (1)
từ A đến Z (4)
Từ A Đến Z (1)
Từ A-Z (1)
Tư bản (1)
Tự do tài chính (23)
Tư duy phản biện (1)
Tự Em Sai (1)
Từ Hy Viên (2)
Từ Hy Viên Chết (1)
Tự Long (1)
Tư mã Ý (4)
Tụ tán thành trang (0)
Tư vấn pháp luật (1)
Tử vi 2025 (1)
Tử vi tuổi hợi (1)
Tự viết theme (2)
Tuấn Hưng (1)
Tuân Úc (1)
Tùng Dương (2)
Từng thi Hoa hậu (1)
Tuổi 32 (1)
Tuổi 54 (1)
Tuổi 65 (1)
Tuổi hợi (1)
Tuổi Hợi 2025 (1)
tuổi U40 (1)
Tương đối hẹp (1)
Tương đối rộng (1)
Tương lai (6)
Tương lai AI (3)
Tương lai smartphone (1)
Tupac Shakur (1)
tuyển sinh (1)
Tuyển tập (24)
Tỷ giá (1)
tỷ giá hối đoái (1)
Tỷ giá MB Bank (1)
Tỷ giá ngoại tệ (1)
Tỷ Phú (6)
Tỷ phú Jack Ma (1)
Tỷ Phú Trung Quốc (1)
UFO (1)
Ukraine (1)
Ukraine đón tin xấu (1)
Ứng dụng (5)
ứng dụng (1)
ứng dụng chi tiết (1)
Ứng Dụng Thực Tế (2)
Ứng dụng trang tính (1)
Unikey (1)
Uniswap (UNI) (1)
Ước mơ (1)
Uptrend (1)
USDT là gì (1)
Út Nhị Mino (1)
ưu đãi (1)
ưu đãi doanh nghiệp (1)
Ưu nhược điểm (2)
ưu nhược điểm (1)
vai diễn bà trùm (1)
Vai trò (1)
Vai trò loa Mid (1)
Vai trò loa Treble (1)
Văn hóa TH Tiến Thịnh (1)
Văn minh cấp 10 (1)
Văn minh cấp 7 (1)
Văn minh tiên tiến (2)
Văn minh vũ trụ (3)
Vận tốc ánh sáng (1)
Vàng (1)
Vang (1)
Vàng ảo (1)
Vàng Kỹ Thuật Số (1)
Vật liệu (1)
Vật liệu chế tạo (1)
Vật liệu tên lửa (1)
Vật lý hiện đại (1)
Vật lý lý thuyết (1)
váy cỏ lau (1)
về quê (1)
Vệ tinh Starlink (1)
VF 8 (1)
VHC (1)
Vi điều khiển (2)
Vi mạch (1)
Ví PayPal (1)
Vì xử lý (1)
vía Ngọc hoàng (1)
Video hài (11)
Việc làm mỹ (1)
viêm đường tiết niệu (1)
Viễn thông (1)
Việt Anh (1)
Việt Nam (2)
Việt Nam điểm đến (1)
Viết theme wordpress (1)
VietBaby Fair (1)
VietinBank (1)
Viettel (3)
Vinamilk (2)
VinaPhone (2)
Vinaresearch (1)
VinFast (4)
VinFast VF 8 (1)
Vĩnh Phúc (1)
Vladimir Putin (1)
Vlogger (3)
Vlogger Phở Đặc Biệt (1)
VNPT (1)
Vợ chồng MC (1)
Vô hạn không (1)
Võ Kiều Vân (1)
Võ Văn Thưởng (1)
Võ Văn Thưởng từ chức (1)
vóc dáng quyến rũ (1)
Voyager 1 (1)
VTC (1)
VTV (3)
VTV1 (1)
Vụ nổ BigBang (1)
Vụ nổ xe (1)
Vũ trụ (5)
Vũ trụ học (3)
Vũ trụ rộng lớn (1)
Vũ trụ và hố đen (1)
Vũ Trụ Vận Hành (1)
Vũ trụ vô hạn (1)
Vua Coffee (1)
Vua hài đất Bắc (1)
vừa lên sóng (1)
Vua Quang Trung (1)
Vua xin tiền (1)
vui đón Tết (1)
Wang Jianlin (1)
Warren Buffett (1)
Wav (1)
Wave Alpha 2025 (1)
Web lừa đảo (1)
Windows 11 (1)
Windows 11 2024 (24H2) (1)
Windows 12 (2)
Windows 2024 (1)
WooCommerce (1)
WordPress (3)
World Cup (1)
Worpress (0)
Xác định đường xu hướng (1)
Xẩm (1)
Xanh SM (1)
Xauusd (0)
Xe 2025 (6)
Xe đáng mua nhất 2025 (1)
Xe đạp (1)
Xe đạp điện (1)
xe điện (2)
Xe điện 2025 (1)
Xe điện đáng mua 2025 (1)
Xe điện Việt Nam (1)
Xe điện VinFast (1)
Xe ga (1)
Xe giá tốt 2025 (1)
xe giảm giá (2)
Xe máy (2)
Xe máy 2025 (1)
Xe máy đáng mua nhất 2025 (1)
Xe máy điện (2)
Xe máy Honda (1)
xe máy và ô tô (1)
xe Mini (1)
Xe mới nhất (2)
xe Peugeot (1)
Xe tay ga (1)
Xe tốt nhất (1)
xe ưu đãi (1)
Xem tử vi (1)
Xếp hạng (1)
Xiaomi (3)
Xiaomi 2024 (1)
xinh như thiên thần (1)
Xịt loramen (1)
XM (0)
Xu hướng (2)
Xu hướng 2025 (2)
Xu hướng đầu tư (1)
Xu hướng định hình (1)
Xu hướng phượt (1)
Xu hướng thị trường (3)
Xu hướng vàng (1)
Xuân Bắc (1)
Xuân Son (1)
Xung đột Nga – Ucraina (2)
Xung đột Trung Đông (1)
Y học 2025 (1)
Ý nghĩa (2)
Y tế (1)
ý tưởng quảng cáo (1)
ý tưởng sáng tạo (1)
Yến Thanh (1)
Zelensky (1)
Zelensky họp khẩn (1)
Danh mục
Chọn Chuyên mục
Âm nhạc (79)
Ẩm thực (1)
Ẩm Thực (20)
Mẹo vào bếp (5)
Việt Nam (10)
Ảnh (1)
Bạn ổn không? (1)
Bất động sản (7)
Chính sách (1)
Dự án (1)
Bí mật kinh tế (6)
Blockchain (4)
Cẩm nang (2)
CAMERA (1)
Chưa phân loại (1)
Chứng khoán & Đầu tư (46)
Chuyện đêm muộn (1)
Chuyện lạ (1)
Công nghệ (0)
Công nghệ AI (3)
Crossword (1)
Cười (1)
Cười (0)
Dấu chân (1)
Điểm đến (4)
Điện thoại (2)
Điện tử (29)
Audio (17)
Đố vui (1)
Đọc chuyện đêm khuya (1)
Đời sống (11)
Bài học sống (1)
Giới trẻ (2)
Tiêu dùng (2)
Tổ ấm (1)
Giá vàng (1)
Giải mã (4)
Giải trí (13)
Giới sao (4)
Nhạc (5)
Phim (1)
Thời trang (2)
Giáo Dục (16)
Chân dung (4)
Du học (0)
Giáo dục 4.0 (6)
tin tức (1)
Trắc nghiệm (0)
Góc nhìn (7)
Hình ảnh (27)
Hồ sơ tội ác (1)
Hộp đen (1)
Hướng dẫn Wordpress (7)
Infographics (4)
Khoa học Công nghệ (33)
Cửa sổ tri thức (7)
Nhân vật (2)
Phát minh (2)
Tin tức. (3)
Việt Nam (1)
Vũ trụ (10)
Kiếm tiền trên mạng (4)
Kiến thức Audio (3)
Kiến thức Trade (32)
Kinh doanh (46)
Doanh nghiệp (4)
Ebank (3)
Hàng Hóa (2)
Netzero (2)
Quốc Tế (1)
Thông tin doanh nghiệp (31)
Tiền Của Tôi (1)
Vĩ mô (1)
Kinh nghiệm (0)
Lịch sử Trung Hoa (29)
Máy tính (4)
Mẹo dân dụng (1)
MP3 (1)
Mua sắm (15)
Thực phẩm chức năng (1)
Ngoại hối-Tiền ảo (16)
Người đương thời (104)
Phân tích kỹ thuật (2)
Pháp luật (3)
Hồ sơ phá án (1)
Tư vấn (1)
Phượt (1)
Plugin (0)
Rao vặt (1)
Review (2)
Sách (2)
Sản phẩm (0)
Sản phẩm tốt nhất (12)
Dịch vụ phát trực tuyến video (1)
Máy tính bảng (1)
Máy tính xách tay (3)
Ti vi (1)
Spotlight (1)
Startup (1)
Sự kiện (4)
Sức khỏe (9)
Bệnh cơ xương khớp (0)
Bệnh dinh dưỡng (0)
Bệnh hiếm muộn (0)
Bệnh hô hấp (1)
Cà Phê & Thức Uống (1)
Sống khỏe (1)
Tài chính (1)
Tài chính cá nhân (1)
Tâm sự (6)
Hẹn hò (1)
Tâm sự Eva (1)
TH Tiến Thịnh (1)
Thế giới (5)
Phân tích (1)
Quân sự (1)
Tư liệu (1)
Thể thao (7)
ASEAN Cup 2025 (1)
Bóng đá (1)
Dữ liệu bóng đá (0)
Lịch thi đấu (1)
Marathon (1)
Tennis (1)
V-League (1)
Theme (3)
Thời Sự (6)
Chính trị (4)
Dân sinh (1)
Thủ thuật mẹo vặt (3)
Thư viện lập trình (4)
Tiền ảo – Tiền điện tử (1)
Tin tức (1)
Tin tức sự kiện (24)
Tin công nghệ (12)
Tin kinh tế (3)
Tin thế giới (5)
Tin thị trường (1)
Topic (3)
Hà Nội (1)
Hậu trường kinh doanh (1)
TP Hồ Chí Minh (1)
Tư vấn (1)
Tử vi (1)
Tương Lai & Công Nghệ (15)
TVN hôm nay (11)
Ứng dụng (3)
Văn hóa giải trí (2)
Vàng Dầu (5)
Về TVN (2)
Ví điện tử (1)
Video (121)
Giải Trí. (30)
Thế giới. (0)
Thể thao. (0)
Thời sự. (0)
Xe. (0)
Việc làm (0)
Web (0)
Xã Hội (1)
Xã Thạch Đà (1)
Xây dựng & lưu trữ web (1)
Xe (13)
Thị trường ô tô (3)
Văn hóa xe (1)
Xe điện (3)
Xe giảm giá (1)
Xe mới (4)
Y học (1)
Ý kiến (7)